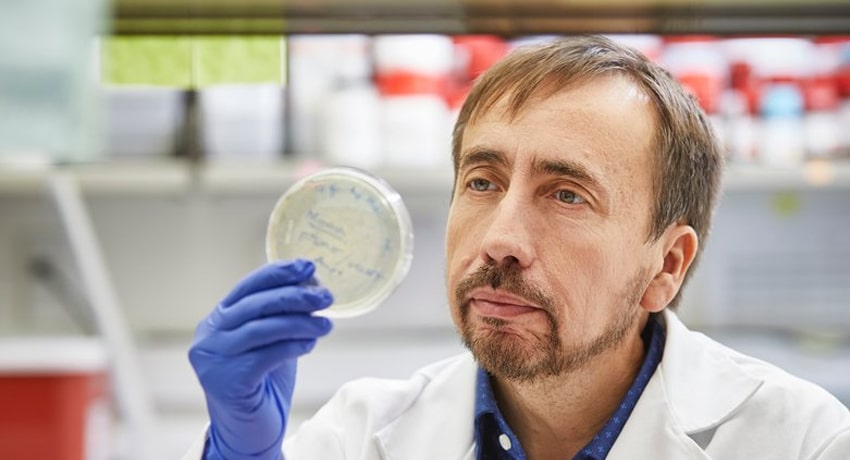
Claudio Soto, PhD, professor and the Huffington Foundation Distinguished Chair in the Department of Neurology with McGovern Medical School at UTHealth Houston. (Photo by UTHealth Houston)

The presence of a misfolded alpha-synuclein protein can be used to determine if people have Parkinson’s disease, according to a new study using technology developed by a researcher at UTHealth Houston. This biomarker could pave the way for the development of better diagnostic tools and new treatment options for the disease.
The study – led by Claudio Soto, PhD, professor and Huffington Foundation Distinguished Chair in the Department of Neurology with McGovern Medical School at UTHealth Houston –was funded in part by the Michael J. Fox Foundation for Parkinson’s Research. The team’s findings were recently published in Lancet Neurology.
Parkinson’s disease is characterized by deposits of a protein known as alpha-synuclein (aSyn) in the nervous system. This protein can become corrupted and start to change shape in a process called misfolding. These misfolded proteins will start to clump together and poison the surrounding healthy nerve cells that are responsible for brain function, particularly for motor skills.
“The findings from our research are a game-changer for Parkinson’s disease,” said Soto, who is also the director of the George and Cynthia Mitchell Center for Research in Alzheimer’s Disease and Related Brain Disorders at UTHealth Houston. “It is rewarding to see that years of work at the university on misfolded proteins and the amplification process will contribute in a substantial way to understanding the pathogenesis of Parkinson’s, and the development of a much-needed therapy.”
Soto is the inventor of patented Protein Misfolding Cyclic Amplification (PMCA) – also termed seed amplification assay (SAA) technology – and is currently the co-founder, chief scientific officer, and board director of Amprion Inc., a biotech company focusing on the commercial utilization of SAA for early diagnosis of Parkinson’s, Alzheimer’s, and other neurodegenerative diseases. Soto and Mohammad Shahnawaz, PhD, assistant professor in the Department of Neurology at McGovern Medical School, are inventors in patented technology on the use of aSyn-SAA for Parkinson’s diagnosis. UTHealth Houston has been working in close collaboration with Amprion to bring this discovery to the benefit of patients worldwide.
Researchers at Amprion studied 1,123 participants who were enrolled at 33 facilities globally between July 2010 and July 2019, representing the largest analysis so far of aSyn-SAA for the biochemical diagnosis of Parkinson’s disease. Of these, 545 had Parkinson’s disease, 163 were healthy people with no evidence of Parkinson’s, 54 had evidence of the disease on brain scans, 51 were in the early stages of the disease, and 310 had genetic mutations that are known to cause Parkinson’s but hadn’t yet done so. This large and well-characterized collection of samples was put together by the Parkinson’s Progression Markers Initiative (PPMI), sponsored by the Michael J. Fox Foundation for Parkinson’s Research.
Using aSyn-SAA as a test in early Parkinson’s detected the disease 87% of the time. Among participants who did not have Parkinson’s, the test showed the absence of the disease 96% of the time.
Interestingly, 30% of participants with the LRRK2 gene mutation – which causes a disease that looks like Parkinson’s – do not have misfolded aSyn, but instead appear to have a different biological disease. In a group of patients who had lost their sense of smell, which is another sign of Parkinson’s, the disease was detected 98.6% of the time.
Significantly, 86% of prodromal, or pre-symptomatic, cases of Parkinson’s disease were positive for aSyn-SAA years before clinical symptoms of the disease appeared, opening the door for an early diagnosis before substantial damage in the brain.
Currently, misfolded aSyn can only be detected by taking a spinal tap, which is an invasive and painful procedure. However, researchers at UTHealth Houston and Amprion are optimizing the aSyn-SAA technology to be utilized to detect the protein in blood, a skin biopsy, or a swab of the nose.
Media Inquiries: 713-500-3030